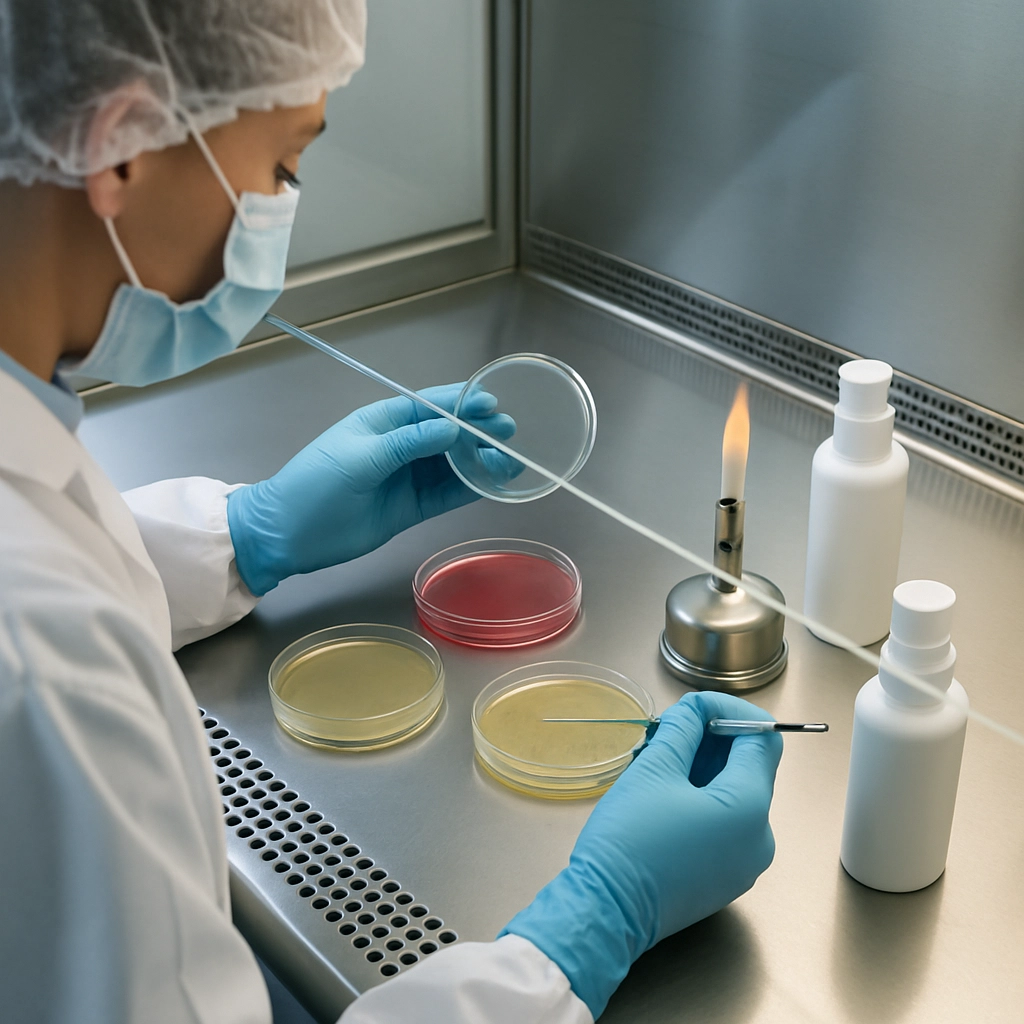
Microbiology testing conducted in lab

Quality & Compliance
GMP rigor for prestige, clean beauty, and OTC products
Audit-ready systems, in-house testing, and disciplined documentation keep every batch on-spec and compliant.
Quality Framework
Controls that protect your brand and consumers
From raw material qualification through finished goods release, our teams follow ISO 22716 GMP practices and OTC controls supported by electronic records and well-trained operators.
- FDA-registered facility with ISO 22716 GMP certification.
- Documented SOPs, batch records, and change controls.
- Comprehensive deviation, CAPA, and internal audit programs.

Testing & Release
In-house labs for fast, reliable decision making
Micro, analytical, and stability programs are integrated with production scheduling to keep timelines on track without compromising quality.
Microbiology
Bioburden, PET/challenge, and environmental monitoring with retained samples and trend reporting.
Stability & Compatibility
Accelerated and real-time stability, packaging compatibility, and shipping simulation to protect shelf life and claims.
Analytical & OTC
Assay, identity, and critical quality attribute testing to support OTC releases and regulated submissions.
Documentation
Traceability from raw material through distribution
- Supplier qualification, COA verification, and incoming inspection with quarantine controls.
- Electronic batch records with line clearance, yield reconciliation, and deviation capture.
- Lot traceability linking raw materials, WIP, and finished goods to retain samples and release data.
Certifications & Standards
Aligned with global expectations
ISO 22716 GMP
Cosmetic GMP certification across production, labs, and warehousing.
FDA Registered
Registered facility with OTC readiness and documented quality systems.
Leaping Bunny
Cruelty-free standards for clients requiring non-animal testing assurances.
USDA Organic Pathways
Ingredient sourcing and handling protocols for organic-compliant products.
Request our quality dossier
Access certifications, SOP overviews, and testing capabilities to streamline your compliance review.